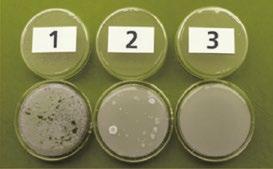

nl| 01.23
Wij geloven dat je enkel door bevlogen vakmanschap de beste laars kan maken. Dat is wat ons als familiebedrijf al 60 jaar bezielt om steeds te gaan voor beter. We innoveren en perfectioneren van generatie op generatie. Van elke stiel kennen we de uitdagingen. Boeren, overal ter wereld, dragen onze laarzen om zeker te zijn van hun oogst. Vissers staan vastberaden op het dek voor de catch of the day. In de voedingssector zorgen onze laarzen voor het hoogste comfort op de werkvloer. Zelfs ambitieuze hobbyisten genieten van onze professionele kwaliteit. We creëren de meest optimale laars voor elke vakman. Zo zorgen we ervoor dat ze elke dag in alle comfort en veiligheid het beste van zichzelf kunnen geven. Goedgelaarsd en vol vertrouwen, klaar voor grootse dingen.
Met onze blik op de toekomst streven we naar échte duurzame meerwaarde. Daarom zetten we ons Belgisch vakmanschap volledig in voor innovatieve oplossingen waar mens en planeet beter van worden. Als pionier kiezen we sinds de beginjaren resoluut voor polyurethaan. Deze uiterst hoogwaardige kunststof zorgt ervoor dat Bekina Boots viermaal langer meegaan! Op die manier zijn onze laarzen voor klanten een duurzame investering die leidt tot minder transport en afval. In alle facetten van onze onderneming kiezen we voor de meest duurzame optie. Van 100% groene energie in ons productieproces tot het stimuleren van biodiversiteit rondom onze gebouwen. Zo werken we samen met onze ganse familie van klanten, medewerkers en partners aan een betere wereld.

Bij Bekina zit doorgedreven vakmanschap in het bloed. Het is de motor van onze niet te stillen innovatiedrang en streven naar de meest duurzame kwaliteit.
Bekina. Innovation through craftsmanship.



Inhoudstafel Neotane 4 De juiste laars voor elke voet 5 Steplite Easygrip 6-7 Steplite Easyclean 8 Getuigenis 11 StepliteX Solidgrip 12-13 Bioveiligheid 14-17 R&D & testing 18-19 StepliteX Thermoprotec 20-21 Riggers 22-23 Inlegzolen en voetbedden 24 Hoe laarzen reinigen? 25 Thermolite Iceshield 26-27 Litefield 28-29 Product overzicht 31
De kracht van Bekina Boots


WAT IS NEOTANE?

Een unieke mengeling van componenten die samen een PU-schuimstructuur vormen. De chemische reactie tussen de verschillende componenten creëert een duurzaam product bestaande uit verschillende lagen en minuscule luchtbelletjes, wat resulteert in:

1 Lichte en flexibele laarzen
2 Optimale thermische isolatie



3 Goed ademend vermogen

X4
3 2 1 NEOTANE
NEOTANE NEOTANE
NAAM SCHACHT
NAAM BUITENZOOL
VEDERLICHT THERMO-ISOLEREND LANEGRE LEVENSDUUR MAKKELIJK AAN EN UIT DANKZIJ UITDUWNOP NEOTANE PVC RUBBER PU gewicht isolatie jaren PVC RUBBER PU PVC RUBBER PU
De juiste laars voor elke voet
DANKZIJ ONS UITGEBREID BEKINA BOOTS ASSORTIMENT, KUNNEN WE IEDEREEN EEN COMFORTABELE VEILIGHEIDSLAARS BIEDEN, VOLGENS IEDERS BEHOEFTE EN VOETTYPE.



OPTIMALE LUCHTSTROOM de brede schacht biedt voldoende luchtcirculatie aan de benen
STANDAARD PASVORM
BREDERE PASVORM
BREDERE KUITEN
KOUDE OMSTANDIGHEDEN
GECERTIFIEERDE VEILIGHEIDSLAARZEN
Zonder veiligheidsneus
Met veiligheidsneus
Met veiligheidsneus en antiperforatiezool
 VEILIGHEIDSNIVEAU
VEILIGHEIDSNIVEAU
composiet composiet
Dé klassieker onder de landbouwlaarzen en synoniem voor comfort en duurzaamheid


Eigenschappen
• Flexibel materiaal, zelfs bij lage temperaturen

• Standaard pasvorm
• Uitstekende grip, ook op natte en gladde oppervlakken (SRC-gecertifieerd)
• Bestand tegen oliën, vetten, mest en chemicaliën

• Makkelijk te reinigen en te desinfecteren
• Laddergrip in buitenzool voor extra veiligheid




Maat:
Kleuren:
Normen en certificaten
Ik breng veel tijd door in mijn Steplite EasyGriplaarzen. Het is dan ook belangrijk dat ze goed aanvoelen en mij niet afmatten. De unieke pasvorm van Bekina Boots biedt mij het nodige comfort.

L. EU 36 - 48 | UK 3.5 - 13 | US 4 - 15 7
Julien
free
+ Bekina Boots inlegzolen
flat sole:

Makkelijk te reinigen en te desinfecteren
Gebruikt door alle bezoekers en werknemers op boerderijen bij uitbraken van nieuwe ziekten (bv. Vogelgriep, Afrikaanse varkenspest, Mond- & klauwzeer… )
Eigenschappen
• Vederlicht
• SRA-gecertifieerd

• Bestand tegen vetten, mest en chemicaliën
• Makkelijk aan en uit dankzij de uitduwnop
• Makkelijk te reinigen en te desinfecteren dankzij de vlakke zool
Maat:
Kleuren:
EU 36 - 48 | UK 3.5 - 14 | US 4 - 16
free
+ Bekina Boots inlegzolen
Perfect voor binnen .



Departement


3 2 2 1 1 3
1 Vuile laarzen
2 Afgespoeld met water
3 Gedesinfecteerd
Bron:
van Landbouw & Visserij/ DGZ / Universiteit Gent
Het comfort van de Bekina Boots
werklaarzen voor de landbouw is echt niet te evenaren.

De mannen bij ons dragen de StepliteX SolidGrip werklaarzen met stalen neus. Die vind ik het meest comfortabel, want ze hebben een brede schacht waardoor je geen beknelling voelt als je er een jeans en overall in draagt. Daarnaast zijn ze heel gemakkelijk te reinigen en kruipt er geen vuil in, wat in ons beroep ook niet onbelangrijk is.
Voor een landbouwer die een hele dag in de stal of op het veld werkt, is comfort het allerbelangrijkste. Met de werklaarzen van Bekina kan ik een hele dag, zelfs dagen aan een stuk bezig zijn zonder pijnlijke voeten of zware benen te krijgen. Dat heb ik met andere laarzen nooit gehad. Het comfort van de werklaarzen van Bekina Boots is echt niet te evenaren.

Dominique

Op zoek naar een
stevig paar laarzen voor
je dagelijkse taken als boer?


Eigenschappen
• Extra hoge veiligheidsneus
• Bredere pasvorm
• Uitstekende grip, ook op natte en gladde oppervlakken (SRC-gecertifieerd)
• Bestand tegen vetten, mest en chemicaliën
• Makkelijk te reinigen en te desinfecteren
• Laddergrip in buitenzool voor extra veiligheid




• Snijbestendig
• Makkelijk aan en uit dankzij de uitduwnop
Maat:
Normen en certificaten :
Ik draag mijn Bekina laarzen elke dag en zou ze niet meer willen missen. Ze passen perfect, zijn comfortabel en vederlicht ondanks de stalen neus en bieden veel grip. Ik ben dol op mijn
Bekina Boots laarzen!


Maria Kyra

EU 36 - 49 | UK 3.5 - 14 | US 4 - 16
free
+ Bekina Boots footbeds
Gebruik andere laarzen per specifieke zone voor een optimaal bioveiligheidsresultaat
aankoop van dieren
voeder en water
reiniging en desinfectie
ingangshygiëne
verwijdering van kadavers
ruiming
Betere Bioveiligheid =
Verhoogde winst
Preventie van ziekteverspreiding
Betere en gezondere productie
Beter deierenwelzijn
Sterkere volksgezondheid en publieke opinie
Conform de wetgeving
Minder antimicrobiële middelen
BIOVEILIGHEID
Bioveiligheid
De snelste, eenvoudigste en goedkoopste manier om verspreiding op de boerderij te voorkomen, is direct ook de meest vergeten maatregel, nl. een goed hygiëne protocol door alle afdelingen op de boerderij; handen wassen en desinfecteren en draag speciale laarzen per zone. Elke kleine inspanning kan een groot verschil maken voor uw bedrijf op elk niveau.
De 2 belangrijkste doelstellingen van bioveiligheid zijn:
1 Preventie van nieuwe ziekten
2 Bestrijding van bestaande ziekten
Binnen deze 2 doelstellingen willen we enerzijds de risico’s beter inschatten en maatregelen nemen om deze risico’s te verminderen. Anderzijds helpt bioveiligheid de gezondheidsstatus op een bedrijf te waarborgen en te verbeteren.
We hebben EXTERNE biobeveiligheid en INTERNE biobeveiligheid.
Externe: introductie van ziekten verminderen
Internal: verspreiding van ziekten beperken
Niet alle transmissieroutes zijn even belangrijk
Ademhaling
Voeder
Huis- en knaagdieren
Lucht
Materiaal
Levende dieren
Transport kleding, laarzen, handen
LAAG RISICO
HOOG RISICO
Advice
Schoeisel vormt een groot risico voor de verspreiding van bacteriën, virussen (bv. vogelpest, Afrikaanse varkenspest, mond- en klauwzeer, mastitis in de omgeving) en andere ziekteverwekkers van buitenaf naar het bedrijf en ook voor de verspreiding van de ene groep dieren naar de andere.
Om uw kudde te beschermen en het gebruik van antimicrobiële middelen te verminderen, is bioveiligheid van het grootste belang en aangezien schoeisel een grote impact heeft, is het raadzaam uw laarzen per zone te scheiden. Zo voorkomt u de verspreiding van ziekteverwekkers van de ene groep naar de andere.
Garaje
Public road
Huis Garage
Parking
Hygiënesluis
Voeder Voeder Voeder
Huis Garage
Hygiënesluis Ziekenboeg
Hygiënesluis
voor zeugen
Ingang Ingang Ingang Hygiënesluis Parking laadkaai Waszone
Zeugen Biggen (batterij) Mestvarkens

voor leveringen
Bioveilligheid Plaats
Huis Ligboxenstal Melktank Vaarzen Parking Trench silo Trench silo
Werktuigen Kalveren
R&D en kwaliteitstesten
Achter elke Bekina laars zit een heel proces van ontwikkeling, innovatie en veiligheidstesten. Daar zorgen we voor in ons eigen testlabo, een modern laboratorium waar we de prestaties en veiligheid van onze laarzen voortdurend onderwerpen aan de nieuwste internationale normen en standaarden.




In ons professioneel laboratorium worden de laarzen onder andere getest op:



1 Antistaticiteit
2 Bescherming met een valtest
3 Onderhevigheid aan slijtage met een Martindale-test
4 Stevigheid met een compressietest
5 Trek- en scheursterkte
6 S5-bescherming van de zool met een perforatietest


7 Slijtage van de zool met een abrasietest
8 Flexibiliteit van de zool (flexing resistance) met een flextest
1 5 6 7 8 2 3 4
In ons labo wordt de kwaliteit van onze producten dagelijks gecontroleerd volgens gestandaardiseerde tests. Hierdoor kunnen wij de garantie bieden dat al onze producten aan de nodige normen en standaarden voldoen. Om een hoge productkwaliteit te garanderen, voeren wij ook een strenge ingangscontrole uit op onze grondstoffen.

Onze veiligheidslaarzen voldoen aan de Europese, Britse, Amerikaanse, Canadese en Australische veiligheidsnormen. Ons laboratorium is uitgerust met de nodige apparatuur om deze tests onafhankelijk uit te voeren. Hiervoor worden wij jaarlijks gecontroleerd door geaccrediteerde instanties.
Bovendien is het laboratorium uitgerust met ultramoderne apparatuur om ons R&D-team te ondersteunen bij onderzoek en ontwikkeling om de nieuwste technologieën en markttrends te implementeren in onze producten met de hoogste duurzaamheid.

Wereldwijd erkende veiligheidsgarantie
Bekina Boots werkt samen met wereldwijd erkende testinstituten. Onze laarzen voldoen zo aan de internationale normen op vlak van veiligheid. Zo kunnen wij aan jou de garantie bieden dat je tijdens het dragen van onze laarzen, zelfs in de meest extreme omstandigheden, steeds de beste bescherming geniet.

Getest en goedgekeurd door professionals
Maar we doen méér dan testen in een labo. Want onze allerbeste garantie op veiligheid en duurzaamheid, dat ben jij. Daarom laten we, wanneer we een vernieuwde laars op de markt brengen, ze langdurig testen door een testpanel van professionals. Ontwikkelen we dus een nieuw paar landbouwlaarzen? Dan worden die eerst getest én goedgekeurd door ons panel van testboeren. Zo voldoen onze laarzen niet alleen aan de internationale veiligheidsnormen, maar ook aan de eisen van de mensen die ze elke dag gaan dragen.
Eigenschappen
• Metaalvrije top en/of zool: maakt de laars lichter en warmer
• Bredere pasvorm
• Uitstekende grip, ook op natte en gladde oppervlakken (SRC-gecertifieerd)
• Dikkere zool: isolatie voor extra warme voeten
• Laddergrip in buitenzool voor extra veiligheid


• Bestand tegen vetten, mest en chemicaliën
• Snijbestendig
Maat:
Kleuren:
Normen en certificaten :
Koude voeten zijn
verleden tijd met StepliteX Thermoprotec, Isoleert tot -40°C.


EU 37 - 48 | UK 4 - 13 | US 5 - 15
+ Bekina Boots footbeds free


Voordelen van lage laarzen: :
• Ideaal voor bredere kuiten
• Ideaal als je snel te warm hebt aan de benen
• Zomers alternatief
• Gemakkelijk tijdens het besturen van voertuigen (tractor, truck)
• De perfecte combinatie tussen veiligheidsschoenen en waterdichte PU-laarzen


Eigenschappen
• Ultralichte instaplaars met treklussen
• Beschikbaar met of zonder wintervoering

• Multifunctionele, slipvaste buitenzool (SRC-gecertifieerd)


• Snijbestendig
• Laddergrip in buitenzool voor extra veiligheid
Maat:
Kleuren:
NIEUW
Normen en certificaten :
Ook beschikbaar in zwart
EU 36 - 49 | UK 3.5 - 14 | US 4 - 16
free
+ Bekina Boots voetbedden
Eigenschappen
• Robuust, toch vederlicht
• Bredere pasvorm
• Uitstekende grip, ook op natte en gladde oppervlakken (SRC-gecertifieerd)

• Laddergrip in buitenzool voor extra veiligheid


• Makkelijk aan en uit dankzij de uitduwnop
• Snijbestendig
• Bestand tegen vetten, mest en chemicaliën
Maat:
Kleuren:
Normen en certificaten :

EU 36 - 49 | UK 3.5 - 14 | US 4 - 16
+ Bekina Boots voetbedden free
INLEGZOLEN VOETBEDDEN
Antibacteriële behandeling neemt geuren op

EU 36 • 49
UK 3.5 • 14
US 4 • 16
Antislip & antistatisch

Schokabsorberend
Klimaatbeheersing
EU 36 • 48
UK 3.5 • 13
US 4 • 15
Ergonomische pasvorm
Schokdempend
30°
Ref. B111
Ref. B101
Geen slijtage
Hoe je laarzen reinigen voor een optimaal resultaat en een langere levensduur?
1 Reinig je laarzen regelmatig met water en een geschikt schoonmaakmiddel* om hun levensduur te verlengen.

2 The inside of the boots should also be cleaned regularly with clean water. Make sure boots are thoroughly dry before putting them back on.
3 Gebruik de juiste dosis was- of reinigingsmiddelen*, zoals aangegeven op de productverpakking
4 Om beschadiging en verkleuring te voorkomen: laat de laarzen niet weken in detergenten of andere chemicaliën
5 Laat de overbroek niet over je laarzen hangen na het werk. De laarzen moeten voldoende kunnen ademen om te drogen.
* Gebruik een neutrale reiniger of ontvetter en een juist ontsmettingsmiddel. Voor de juiste producten kan je terecht bij jouw hygiëneleverancier. Lees altijd het etiket voordat je professionele reinigings- en ontsmettingsmiddelen gebruikt.
25
Ze zijn stevig met een zeer goede grip zodat we nooit uitglijden of vallen. Bovendien houden ze onze voeten warm tijdens het wassen van de prei. Maar het allerbeste aan de landbouwlaarzen van Bekina Boots is dat ze niet knellen aan de kuiten dankzij de bredere schacht.

Eigenschappen
• Sterke grip (SRC-gecertifieerd)


• dikke zool: koude isolatie voor extra warme voeten
• Schokabsorberende hiel

• Ladder grip in sol for extra security
• Bestand tegen vetten, mest en chemicaliën .
Maat:
Kleuren:
Normen en certificaten :
Ivo EU 39 - 47 | UK 6 - 12 | US 6 - 14
free
+ Bekina Boots voetbedden

De elegante
vrijetijdslaars,

ideaal voor elke buitenactiviteit!


Eigenschappen
• Stijlvol en elegant
• Smalle pasvorm
• Comfort: Vederlichte en flexibele hoge schacht


• Schokabsorberende hiell

• Laars geschikt voor kleine klusjes, wandelingen en werken in de tuin
free
Maat:

Kleuren:
Ik draag Litefield graag om met mijn paarden naar de weide te gaan. Deze laarzen zijn soepel en licht, maar vooral de uitduwknop vind ik heel handig!
Hilde De Ruyver
EU 36 - 47 | UK 3.5 - 12 | US 4 - 14
+ Bekina Boots inlegzolen
















veiligheid kleur
PAN1P/9180A ISO 20347:2012 PAN1P/1053A PAN3P/9180A ISO 20345:2011 PAN3P/1053A PAN3P/5353A PAN4P/9180A ISO 20345:2011 PAN4P/2080A PAN4P/8080A PAD1P/9180A ISO 20347:2012 XAN1P/9180A ISO 20347:2012 XAN3P/9180A ISO 20345:2011 XAN3P/1053A XAN3P/5353A XAN4P/9180A ISO 20345:2011 XAN4P/2080A XAN9P/8080A ISO 20345:2011 XMN1P/9180A ISO 20347:2012 XMN4P/9180A ISO 20345:2011 XRN4P/7080A ISO 20345:2011 XRN4P/8080A XFN4P/7080A ISO 20345:2011 XFN4P/8080A XAS9P/5562Y ISO 20345:2011 XAC8P/1053A ISO 20345:2011 XAC9P/9180A XAC9P/6253A ZAN4P/9180A ISO 20345:2011 SAN1P/9170A /
Product code certificaten
www.bekina-boots.com